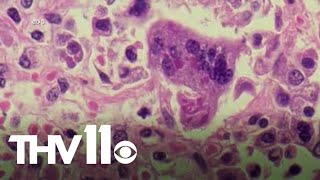

Fourth measles case in Arkansas contracted by community spread video
Online izle ve mp4 mp3 formatlarinda yukle
Videonun muddeti: 2:03
Fourth measles case in Arkansas contracted by community spread videosu mp4 ve mp3 yuklemek ucun hazirdir
Diqqet! Siz Mp4 yukle ve ya Mp3 yukle duymesine basdiqdan sonra eger sistem sizi reklam sehifesine atarsa o zaman derhal geri qayidib emeliyyati tekrar edin ve faylin yuklemek ucun hazir olmasini gozleyin
Videodan Mp4 Yukle
Videodan Mp3 Yukle-1
Videodan Mp3 Yukle-2
Oxshar Axtarishlar
Fourth measles case in Arkansas contracted by community spread
Arkansas health officials confirm fourth measles case
ADH confirms fourth measles case in Arkansas
Fourth measles case confirmed in Arkansas
ADH confirms fourth measles case in the state
Doctors urge for preparations amid measles outbreak
Arkansas Measles Cases
Arkansas health officials confirm first case of measles in 2025
Two positive measles cases now reported in Arkansas
Video Mp4 Mp3Azwap.Biz
Azwap.Biz 2021-2023